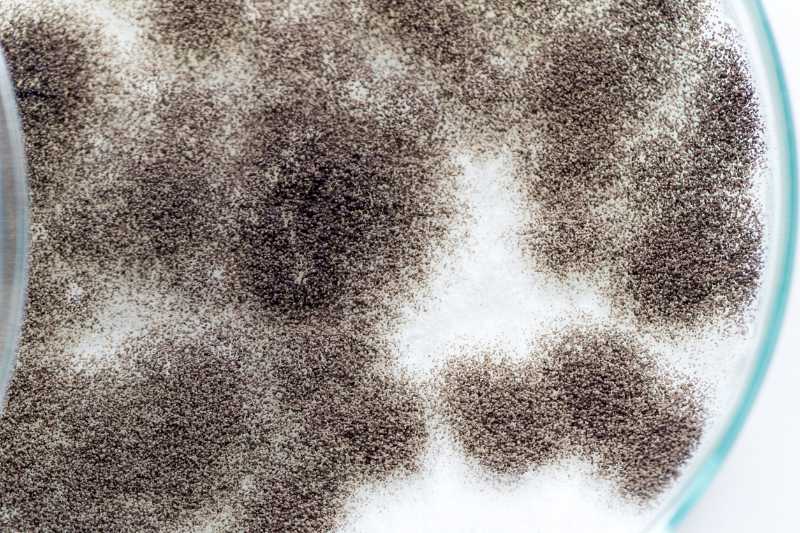
Asperillus Niger in Petrischale

Suche
Suche
Sie befinden sich hier: Startseite > Hygiene > Gefahren für Lebensmittel > Aspergillus niger
Aspergillus niger
Aspergillus niger gehört zur Gattung Aspergillus und ist im Deutschen unter dem Namen Schwarzschimmel oder Schwarzer Gießkannen-Schimmelpilz bekannt (Abbildung 1).
Abbildung 1: Aspergillus niger in einer Petrischale (Foto: Sinhyu, Thailand)
Charakteristisch sind die schwarz bis schwarz-braunen Konidiosporen, die an den Konidienträgern ausgebildet werden (siehe Abbildung 2). Der Schwarzschimmel ist weltweit auch in extremen Klimazonen, wie Wüsten, Salzmarschen und Mangrovenschlamm vorzufinden. A. niger hat ein weites Spektrum für das Wachstum, so liegt das Temperaturminimum zwischen 6 °C und 8 °C und das Maximum bei 45 °C bis 47 °C [4]. Optimale Wachstumsbedingungen findet der Schwarzschimmel bei Temperaturen zwischen 35 °C und 37 °C vor; dieses Optimum macht es ihm möglich im menschlichen Körper zu überleben [4] (→ Schimmelpilz).

Abbildung 2: Schema eines Konidienträgers mit Konidiosporen
Schimmelpilzbefall mit Aspergillus-Arten findet sich bei Getreide und
Backwaren, Obst und Gemüse sowie Käse- und Joghurtprodukten. Neben
Lebensmitteln können sie auch Papier und Tapeten zerstören, hinterlassen
Korrosionsspuren auf Metallen und greifen kalkhaltige Gesteine wie
Marmor sowie Leder, Textilien aus Pflanzenfasern und Farbanstriche an. Aspergillus niger führt auch zur Verätzung und Trübung von Plexiglas und Verminderung der Reißfestigkeit und Elastizität von Kunststoff und
Gummi. Bei Bauarbeiten passiert es häufig, dass Aspergillus-Sporen aus Dämmstoffen freigesetzt werden [4, 6].
Früher wurde Aspergillus niger u. a. zur Produktion von
Zitronensäure und Pektinase genutzt. Das Verfahren gilt heute als
veraltet [3].
Schwarzschimmel kann aber auch Mykotoxine wie ![]() Koji- und
Koji- und ![]() Oxalsäure bilden [1].
Oxalsäure bilden [1].
Die Sporen stehen im Zusammenhang mit ganz unterschiedlichen
Krankheiten, sie verursachen Infektionen wie → Aspergillose oder pilzbedingte
allergische Nasennebenhöhlenentzündung (AFS-Syndrom - Allergic Fungal
Sinusitis) [4].
Infektionsweg
Sporen der Aspergillus-Arten, so auch von Aspergillus niger,
finden sich überall in der Luft. Sie werden eingeatmet und gelangen so in die Lunge und können dort in seltenen Fällen eine Lungenentzündung auslösen. Häufiger sind die Ohren, die Haut oder die oberen Atemwege betroffen. Meist wird Aspergillose durch → Aspergillus fumigatus ausgelöst.
Bei gesunden Menschen löst das Einatmen der Aspergillus-Sporen in der Regel keine Infektionen aus. Zu einer Erkrankung kann es beispielsweise kommen, wenn das Immunsystem geschwächt ist oder eine Lungenerkrankung wie Asthma vorliegt. Es findet keine Übertragung von Mensch zu Mensch statt [5, 3, 6].
Mykotoxine (Schimmelpilzgifte) können mit Lebensmitteln aufgenommen werden. Werden Rohstoffe wie Getreide, Nüsse und Mandeln während des Anbaus, der Lagerung oder der Weiterverarbeitung von Schimmelpilzen befallen, können sie später auf die verarbeiteten Produkte übergehen [11].
Inkubationszeit
keine Angaben
Krankheitsverlauf
Aspergillose bezeichnet ein weites Feld an Infektionskrankheiten, die durch die Gattung Aspergillus hervorgerufen werden. Betroffen werden kann so ziemlich jedes Organ im Körper.
Allergische bronchopulmonale Aspergillose (ABPA): ist eine allergische Reaktion auf eingeatmete Aspergillus-Schimmelpilze. Gewöhnlich sind Menschen mit Asthma oder zystischer Fibrose (Mukoviszidose) betroffen. Symptome sind Keuchen, Atemnot, Husten und in seltenen Fällen Fieber [3, 5, 7, 8].
Aspergillom: Hierbei handelt es sich eine Ansammlung aus Pilzbestandteilen und Schleim, die einen sogenannten „Pilzball“ bilden. Das Aspergillom bildet sich meist in einem bestehenden Hohlraum, wie zum Beispiel den Nasennebenhöhlen oder der Lunge. Symptome sind z. B. Husten und Atemnot [3, 6, 7].
Invasive Aspergillose Aspergillus-Lungenentzündung: Eine schwere Infektion, die in der Regel Menschen mit einem geschwächten Immunsystem betrifft, wie z. B. Menschen nach einer Organ- oder Stammzelltransplantation. Die invasive Aspergillose beginnt häufig in den Atemwegen und den Nasennebenhöhlen. Von hier aus kann sich die Aspergillose auf andere Teile des Körpers wie Gehirn, Leber, Nieren, Haut und Darm ausbreiten [3, 6, 7, 9].
Prävention
Es ist nicht möglich Schimmelpilz-Sporen auszuweichen, weil sie überall vorhanden sind. Mit einigen Maßnahmen können Sie jedoch das Risiko einer Aspergillose senken [5].
Vermeiden Sie Orte, an denen häufig Schimmel auftritt. Der britische NHS nennt hier insbesondere Komposthaufen, Gegenden mit Bäumen, Pflanzen, Feldfrüchten und verrottenden Blättern, staubige Orte, feuchte Gebäude und Klimaanlagen [5].
Beheizen Sie bei kaltem Wetter die Räumlichkeiten auf Temperaturen zwischen 18 und 21 °C [5].
Lüften Sie regelmäßig, insbesondere wenn Sie gekocht oder geduscht haben. Vermeiden Sie jedoch ein Fenster zu öffnen, wenn draußen Bauarbeiten stattfinden oder Erde ausgehoben wird [5].
In einigen Fällen kann es sinnvoll sein einen Luftentfeuchter und einen Luftreiniger mit HEPA-Filter einzusetzen [5].
Tragen bei Reinigungsarbeiten im Haus eine FFP2 Maske / N95 Maske oder besser. Für Renovierungsarbeiten und wenn Sie mit Erde umgehen oder Blumen umtopfen wird das Tragen einer FFP3 Maske / P100 Maske empfohlen. Um die Anzahl schwebender Partikel in der Luft zu reduzieren kann ein Feinfilter (HEPA-Filter) für den Staubsauger helfen [2].
Allgemeine Prävention bei Schimmelpilz
Um Lebensmittel vor Schimmelbefall zu schützen, sollten sie kühl und trocken gelagert werden.
Lebensmittel mit sichtbarem Schimmelbefall dürfen nicht mehr verzehrt werden. Da die Hyphen eines Schimmelpilzes farblos sind, kann man davon ausgehen, dass der Schimmelpilz viel weiter reicht, als man mit bloßem Auge erkennen kann.
Fallen bei Lebensmitteln unangenehme Gerüche oder Verfärbungen auf, zum Beispiel beim Schälen von Nüssen, sollten diese nicht mehr gegessen werden [10].
Arbeitsgeräte nach dem Schneiden von beispielsweise Edelschimmelkäse gründlich reinigen.
Interessanter Link
![]() Bundesinstitut für Risikobewertung (BfR) (2026): Fragen und Antworten ─ Schimmelpilze in Lebensmitteln – Gesundheitliche Risiken und wie sie sich vermeiden lassen. Zugriff am 22.04.2026
Bundesinstitut für Risikobewertung (BfR) (2026): Fragen und Antworten ─ Schimmelpilze in Lebensmitteln – Gesundheitliche Risiken und wie sie sich vermeiden lassen. Zugriff am 22.04.2026
Quellen
[1] ![]() Thomas Paatsch VDI: Aspergillus niger. Zugriff am 11.12.2017
Thomas Paatsch VDI: Aspergillus niger. Zugriff am 11.12.2017
[2] ![]() Aspergillosis Patients & Carers Support: Facemask Guidance for ABPA (Allergic Bronchopulmonary Aspergillosis) Patients. Zugriff am 10.02.2026
Aspergillosis Patients & Carers Support: Facemask Guidance for ABPA (Allergic Bronchopulmonary Aspergillosis) Patients. Zugriff am 10.02.2026
[3] Pschyrembel Klinisches Wörterbuch. 268. Auflage. 2020
[4] Kück, Nowrousian, Hoff, Engh: Schimmelpilze: Lebensweise, Nutzen, Schaden, Bekämpfung. 2009
[5] ![]() NHS (Hrsg.): Aspergillosis. Letzte Überprüfung 19.04.2024
NHS (Hrsg.): Aspergillosis. Letzte Überprüfung 19.04.2024
[6] ![]() Wort & Bild Verlag Konradshöhe GmbH & Co. KG (Hrsg.): Aspergillose: Wenn Schimmel krank macht. Zugriff am 12.02.2026
Wort & Bild Verlag Konradshöhe GmbH & Co. KG (Hrsg.): Aspergillose: Wenn Schimmel krank macht. Zugriff am 12.02.2026
[7] ![]() Centers for Disease Control and Prevention (Hrsg.): Aspergillosis. Zugriff am 12.02.2026
Centers for Disease Control and Prevention (Hrsg.): Aspergillosis. Zugriff am 12.02.2026
[8] ![]() Jean-Paul Latgé: Aspergillus
fumigatus and Aspergillosis, Clinical Microbiology Reviews, April 1999
Jean-Paul Latgé: Aspergillus
fumigatus and Aspergillosis, Clinical Microbiology Reviews, April 1999
[9] ![]() Leibniz-Insitut für Naturstoff-Forschung und Infektionsbiologie - Hans-Knöll-Institut: Invasive Aspergillose. Die Organismen. Zugriff am 12.02.2026
Leibniz-Insitut für Naturstoff-Forschung und Infektionsbiologie - Hans-Knöll-Institut: Invasive Aspergillose. Die Organismen. Zugriff am 12.02.2026
[10] ![]() Bundesamt für Verbraucherschutz und Lebensmittelsicherheit (BVL) (Hrsg.): Schimmelpilzgifte in Lebensmitteln. Zugriff am 12.02.2026
Bundesamt für Verbraucherschutz und Lebensmittelsicherheit (BVL) (Hrsg.): Schimmelpilzgifte in Lebensmitteln. Zugriff am 12.02.2026
[11] ![]() Bundesinstitut für Risikobewertung (BfR) (2026): Stellungnahme ─ Mykotoxine in Soja-, Mandel- oder Haferdrinks: BfR aktualisiert die Bewertung gesundheitlicher Risiken von Pflanzendrinks anhand neu erhobener Daten. Zugriff am 17.02.2026
Bundesinstitut für Risikobewertung (BfR) (2026): Stellungnahme ─ Mykotoxine in Soja-, Mandel- oder Haferdrinks: BfR aktualisiert die Bewertung gesundheitlicher Risiken von Pflanzendrinks anhand neu erhobener Daten. Zugriff am 17.02.2026
W. Mücke, Ch. Lemmen: Schimmelpilze Vorkommen, Gesundheitsgefahren Schutzmaßnahmen, 2004